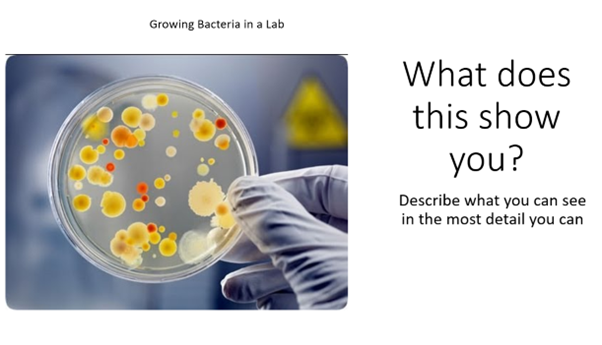
pub, 105.5 KB

Fully Resourced Lesson – Growing Bacteria in the Lab (NEW AQA Trilogy Biology GCSE)
Perfect for the AQA GCSE Biology Trilogy specification – Topic: Infection & Response – Culturing Microorganisms
This high-quality, ready-to-use lesson pack has everything you need to deliver an outstanding lesson to mixed-ability classes (content grades 1–8 covered).
Included in this complete lesson bundle:
- Clear lesson objective & differentiated success criteria
- Engaging information slides with stunning visuals
- Built-in challenge & stretch activities
- Varied “demonstrate understanding” tasks (exam-style questions, retrieval practice, etc.)
- Full set of printable/digital worksheets and resources tailored for mixed-ability teaching
Everything is carefully differentiated and designed to save you hours of planning while ensuring every student makes progress.
Instant download – ready to teach today!
For any questions, feel free to get in touch:
bioeducation@gmail.com
Get this resource as part of a bundle and save up to 70%
A bundle is a package of resources grouped together to teach a particular topic, or a series of lessons, in one place.
Something went wrong, please try again later.
This resource hasn't been reviewed yet
To ensure quality for our reviews, only customers who have purchased this resource can review it
Report this resourceto let us know if it violates our terms and conditions.
Our customer service team will review your report and will be in touch.